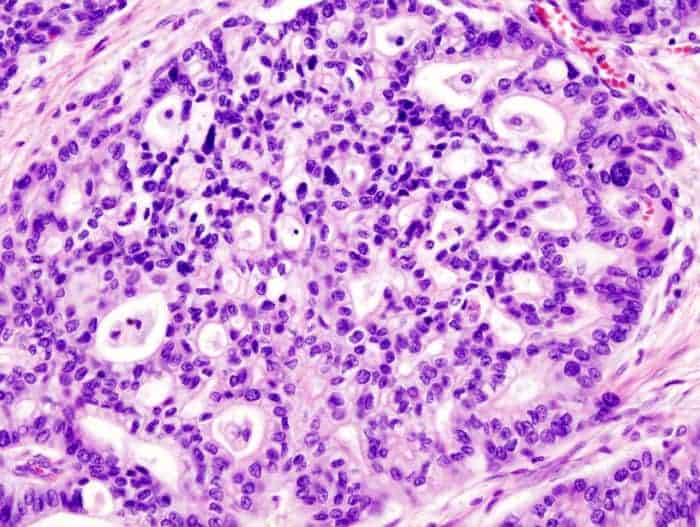
Pancreatic Adenocarcinoma

Adding Heparin to IV’s to Avoid Thrombosis
Question: I am confused as some of your old notes and other clinicians recommend adding…
Dr. Anderson's Web TeamJune 10, 2019